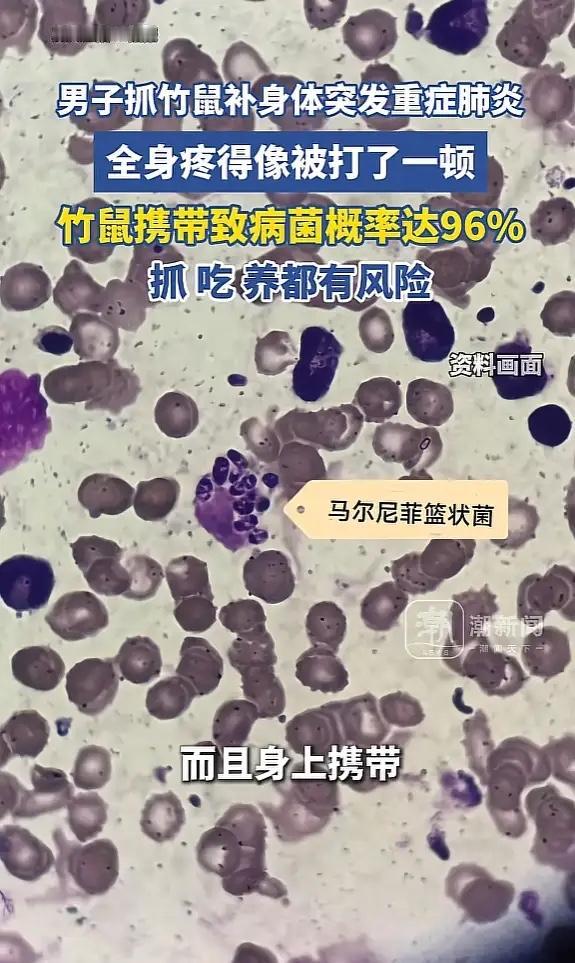

“悲剧还是发生了!”浙江杭州,一男子为滋补身体,就将野生竹鼠抓来吃,结果平时健康的身体竟突发高烧,全身像被人揍了一顿,硬扛一周后病情恶化,去医院检查,才发现自己的肺“烂穿了”,并且呼吸衰竭,再拖下去就有生命危险! 男子听人说竹鼠特别补,冬天吃一碗能暖身壮骨,就在家附近的山上抓了一只野生竹鼠,自己宰杀炖汤喝了。吃完没多久,男子就开始发高烧,体温直逼40度。他感觉全身骨头缝里都疼,像被人狠狠打了一顿。他以为自己能扛过去,硬撑了一周。 等到实在撑不住去医院CT检查显示他的双肺布满了阴影,有些地方已经出现空洞,像是被什么东西“啃”过一样。他的血氧饱和度掉到了70%以下,正常人是95%以上。医生诊断是重症肺炎、I型呼吸衰竭,立刻把他送进病房抢救。 经过详细检查,医生查出是马尔尼菲篮状菌感染。这种真菌以前叫马尔尼菲青霉菌,人和竹鼠是它仅有的两个宿主,男子在抓竹鼠、宰杀处理的过程中,很可能吸入了或者接触到了这种真菌。这种菌感染后不一定马上发病,能在人体里潜伏下来,有些甚至能“隐藏”十年之久,等到人免疫力下降时才会突然发作。一旦发作起来就很凶险,如果没有得到及时、正确的治疗,死亡率非常高。 经过一段时间的紧张治疗,男子的呼吸衰竭症状总算缓解了,肺部病灶也开始吸收好转。虽然能出院回家,但仍需要继续用药巩固,定期回医院复查。 很多人觉得野味更天然、更补,这是一个很大的误区。野生竹鼠活跃的区域,不仅直接捕食有风险,接触它们的生活环境,比如洞穴、被粪便污染的土壤,也可能中招。 各位读者你们怎么看?欢迎在评论区讨论。

评论列表